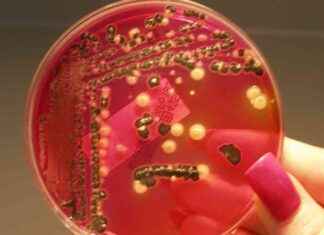
Hava Koşullarının Salmonella Bulaşımı Üzerindeki Etkisi Araştırıldı hava-koullarnn-salmonella-bulam-zerindeki-etkisi-aratrld

NeuroFlow, Quartet Health Satın Alarak Müşteri Tabanını Genişletiyor
NeuroFlow, Quartet Health Satın Alarak Müşteri Tabanını Genişletiyor NeuroFlow, bir davranışsal sağlık teknolojisi ve analiz şirketi olarak, sanal zihinsel ve davranışsal sağlık platformu Quartet Health'i satın aldığını duyurdu ve anlaşmanın Ocak ayı sonunda sonuçlanması bekleniyor. NeuroFlow'un...
Bağırsak Kaynaklı Şekerler: Kilo Kontrolü ve Diyabet İçin Potansiyel Bir Oyun Değiştirici
Bağırsak Kaynaklı Şekerler: Kilo Kontrolü ve Diyabet İçin Potansiyel Bir Oyun Değiştirici Son dönemde yayınlanan bir çalışma, bağırsak mikrobiyotasından elde edilen ekzopolisakkaritlerin (EPS) metabolik düzenleme ve konak fizyolojisi üzerindeki rolünü araştıran araştırmacıları inceledi. Arka Plan Metabolik bozukluklar...
Erken yaşlanma ve bilişsel gerileme EKG testleri ve yapay zeka ile tespit edilebilir
Erken Yaşlanma ve Bilişsel Gerileme EKG Testleri ve Yapay Zeka ile Tespit Edilebilir Çalışmalar gösteriyor ki, elektrokardiogram (EKG) testleri bir yapay zeka modeli ile birleştirilerek erken yaşlanma ve bilişsel gerilemeyi tespit etmek için kullanılabilir. Bu...
Yardımcı Arılar, yaşlanma yerinde platformunun genişlemesi için 35 milyon doları güvence altına alıyor.
Yaşlanma Yerinde Platformunun Genişlemesi İçin Yardımcı Arılar, 35 Milyon Dolar Topladı Yardımcı Arılar, yaşlıların yaşamı ve yaşlanması üzerine odaklanan bağımsız bir teknoloji platformu, Seri C fonlama turunda 35 milyon dolar topladığını duyurdu. Centana Growth Partners...
Guinea, Afrika Uyuz Humani Trypanosomiasis’i Yok Etmede WHO’dan Övgü Aldı.
WHO, Guinea'dan ilan ettiği gambiyense formu insan Afrika uyuz humani trypanosomiasis'in halk sağlığı sorunu olarak ortadan kaldırması nedeniyle Gine'yi tebrik ediyor. Bu form, Gine'de bulaşan tek türdür ve ülkede ortadan kaldırılan ilk ihmal edilmiş...
Kırsal Sorunları Ele Alan Robert F. Kennedy Jr.’ın AI Hakkında Görüşleri
Robert F. Kennedy Jr. Heat Hakkında Görüşlerini Paylaştı Robert F. Kennedy Jr., Trump'ın sağlık ve insan hizmetleri bakanlığını yönetmek için atadığı kontroverziyal isim, Çarşamba günü Senato Maliye Komitesi önünde gerçekleşen onaylama duruşmasında, kırsal hastanelerin bir...
Yeni İlaç Regimenleri Dirençli Verem İçin Umut Vadeder
Yeni İlaç Regimenleri Dirençli Verem İçin Umut Vadeder Dünya çapında enfeksiyöz hastalık öldürücülerinden biri olan tüberküloz, hastalığın ilaçlara dirençli formları tarafından daha da zor bir hale getirilmektedir. Şimdi, uluslararası bir klinik denemede, tüberküloza karşı rifampine...
SafelyYou, AI Destekli Yaşlı Bakımı İçin 43 Milyon Dolar Yatırım Alıyor
SafelyYou, AI Destekli Yaşlı Bakımı İçin 43 Milyon Dolar Yatırım Alıyor SafelyYou, düşme tespiti ve önlenmesi için AI destekli teknoloji üreten bir şirket, Touring Capital liderliğinde gerçekleşen 43 milyon dolarlık Seri C finansman turunu tamamladı...
Retinoblastoma’da Potansiyel Kazanç Fonksiyon Mutasyonu Belirleniyor
Retinoblastoma'da Potansiyel Kazanç Fonksiyon Mutasyonu Belirleniyor Genlerimiz, sağlığımız için kritik öneme sahip olan birçok süreci yönetir. Ancak, bazen bu genlerde meydana gelen değişiklikler, ciddi sağlık sorunlarına yol açabilir. Bu bağlamda, retinoblastoma isimli göz kanserine yönelik...
Alzheimer Hastalığı İçin Grey Matter Nörobilim $14 Milyon Yatırım Alıyor
Grey Matter Nörobilim, Alzheimer hastaları için bir ultrason başlığı geliştirmek ve bu cihazı klinik denemelerde test etmek için 14 milyon dolar yatırım aldığını duyurdu. Finansmanı, Witington İnovasyon Fonu liderliğinde, Toronto İnovasyon Hızlandırma Ortakları, Ontario...
Hava Koşullarının Salmonella Bulaşımı Üzerindeki Etkisi Araştırıldı
Klima Değişikliğinin Salmonella Bulaşımı Üzerindeki Etkisi Son araştırmalara göre, klima değişikliği Salmonella'nın yayılmasını etkiliyor. Surrey Üniversitesi'nden yeni bir çalışma, tehlikeli ishal hastalığının yayılmasının hava değişikliği tarafından yönlendirildiğini ortaya koydu. Surrey Veterinerlik Fakültesi'ndeki bir araştırma ekibi...
AI Destekli Eleos, Davranışsal Sağlık İçin 60 Milyon Dolarlık Yatırımı Güvence Altına Aldı
AI Destekli Eleos, Davranışsal Sağlık İçin 60 Milyon Dolarlık Yatırımı Güvence Altına Aldı Eleos adlı bir yapay zeka davranış sağlık şirketi, toplam fonunu 120 milyon doların üzerine çıkaran bir Seri C finansman turunda 60 milyon...
Erken Doğan Bebeklerde Ağrı Yönetimindeki Boşlukları Ortaya Koyan İsveç Çalışması
İsveçli araştırmacılar, erken doğan bebeklerde ağrının iyileştirilmesi için geliştirilmesi gerekenlerin altını çiziyor. PAIN dergisinde yayımlanan bir araştırma, bu hassas yeni doğanlarda ağrının yaygınlığı, nedenleri ve tedavisi konusunda ışık tutuyor. Araştırmacılar, dört yıldan fazla detaylı...
Yenidoğan Sağlığı İçin Owlet360 Abonelik Servisi Tanıtıldı.
Yenidoğan Sağlığı İçin Owlet360 Abonelik Servisi Tanıtıldı Çocuk teknolojisi şirketi Owlet, bakıcıların bebeklerinin gelişim ve sağlık durumlarıyla ilgili verilere erişebileceği Owlet360 adlı bir abonelik hizmetinin başlatıldığını duyurdu. Owlet360, bir bebekle ilgili sağlık ve uyku verilerinin...
Periferik Sinir Kılıfı Tümörleri için Yeni Tedavi Yöntemi
Periferik Sinir Kılıfı Tümörleri İçin Yeni Tedavi Yöntemi: Uzmanların İzinden Bilimsel Araştırmalarda İspanyol araştırmacılarından oluşan çok merkezli bir ekip, Bellvitge Biyomedikal Araştırma Enstitüsü (IDIBELL) - Katalan Onkoloji Enstitüsü (ICO) ve Alman Trias i Pujol Araştırma...
Uzmanlık Bakımında Sağlık ve Kişiselleştirilmiş Sağlık Araçları Hakkında SSS
Uzmanlık Bakımında Sağlık ve Kişiselleştirilmiş Sağlık Araçları Hakkında SSS Robin Cherry Glass, San Francisco'daki şirketinin ofisinde JPM Healthcare Konferansı'nda konuşmak üzere oturan ve sanal bakım şirketi Included Health'in başkanı olan kişi, şirketin uzmanlık bakımı ve...
BEND Lipidler mRNA Teslimatını ve Gen Düzenlemeyi Devrim Yapıyor
Lipidlerin mRNA Teslimatını ve Gen Düzenlemeyi Devrim Yapan BEND Her bir mekik Uluslararası Uzay İstasyonu'na (ISS) yanaştığında, mekiklerin yanaşma sistemi ile istasyondaki karşılıklı sistemi arasında hassas bir dans gerçekleşir. Uluslararası standartlar sayesinde, bu mekanizmalar evrensel...
LinkedIn Kurucularından Birisi, Yapay Zeka İlaç Keşfi İçin 24.6 Milyon Dolar ile Manas AI’ı...
LinkedIn'in kurucularından biri olan Reid Hoffman, yapay zeka destekli ilaç keşfi platformu Manas AI'ı 24.6 milyon dolarlık bir yatırım turuyla başlattı. Genel Catalyst ve LinkedIn'in kurucularından Reid Hoffman tarafından yönetilen bir turda başlatılan bu...
Çocuklarda Uzun Süreli COVID’e Sahip Olanlar Arasında Farklı Kan Protein İmzası Tespit Ediliyor
Çocuklarda Uzun Süreli COVID'e Sahip Olanlar Arasında Farklı Kan Protein İmzası Tespit Ediliyor Son COVID-19 pandemisi, dünya genelinde milyonlarca insanı etkiledi. Ancak, çocuklar genellikle hafif semptomlarla atlatan ve hızla iyileşen grup arasındaydı. Ancak, son zamanlarda...
Kadın Sağlığı Platformu İçin Allara Health 26 Milyon Dolar Topladı.
Kadın Sağlığı Platformu Allara Health, Seri B fonlama turunda 26 milyon dolar topladı. Bu yatırım, toplam yatırımını 38.5 milyon dolara çıkardı. Yatırım turunu Index Ventures liderliğinde, mevcut yatırımcı GV (Google Ventures) da katılım gösterdi. Ne...
Elucent Medical, Cerrahi Teknoloji Şirketi, $30M Yatırımı Güvence Altına Alıyor
Elucent Medical, Cerrahi Teknoloji Şirketi, $30M Yatırımı Güvence Altına Alıyor Elucent Medical, yönlendirilmiş cerrahi teknoloji şirketi, Trinity Capital'dan 30 milyon dolarlık büyüme sermayesi alacak. Ne Yapıyor? Elucent Medical'ın bayrak gemisi ürünü EnVisio Sistemi, SmartClip işaretleyici ve SmartSensor'u...
Cerrahi Kolorektal Kanser Etkinliğini Değerlendirmede cfDNA Seviyelerinin Takibi Önemli
**Cerrahi Kolorektal Kanser Etkinliğini Değerlendirmede cfDNA Seviyelerinin Takibi Önemli** Bir grup araştırmacı, 21 Ocak 2025 tarihinde Oncotarget'in 16. cildinde yayınlanan "Assessment of cfDNA release dynamics during colorectal cancer surgery" başlıklı yeni bir araştırma makalesi yayınladı. Brasília...
Beslenme Müdahalesi Bağırsak Florasını Onarır ve Kronik Hastalıklara Karşı Koruma Sağlar
Beslenme Müdahalesi Bağırsak Florasını Onarır ve Kronik Hastalıklara Karşı Koruma Sağlar Son zamanlarda Cell dergisinde yayımlanan bir araştırmada, araştırmacılar sağlıklı yetişkinlerde mikrobiyom geri kazanımı stratejisinin etkilerini inceledi. Arka Plan İnsanlar, konak gelişimi, sağlık ve uygunluk üzerine katkıda...
Evde Kullanılan Cannabis Dumanı ve Çocuklardaki İkinci El Maruziyet
Title: İçeride Kullanılan Cannabis Dumanı ve Çocuklardaki İkinci El Maruziyet Bir araştırma ekibi, JAMA Network Open'da yayınlanan son bir çalışmada, ABD'den gelen araştırmacılar, evde cannabis içmenin çocuklar arasında ikinci el maruziyeti üzerindeki ilişkiyi araştırdı ve...
Cerrahiden sonra celecoxib ile fayda sağlayan hastaları tanımlayan ctDNA kan testi
Title: Cerrahiden Sonra Celecoxib ile Fayda Sağlayan Hastaları Tanımlayan ctDNA Kan Testi Bir veri analizi, Dana-Farber Brigham Kanser Merkezi'ndeki araştırmacılar tarafından yapılan randomize klinik bir çalışmadan, cerrahi ile kanseri çıkarttıktan sonra kanlarında kalan kanser belirtileri...